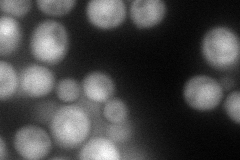
YKR104W
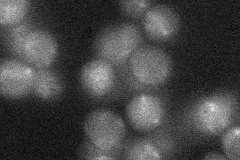
YKR104W

View description
Putative transporter of the multidrug resistance-associated protein (MRP) subfamily; contains a stop codon in S288C; adjacent ORFs YKR103W and YKR104W are merged in different strain backgrounds
Localization:
Intensity:
Fold change:
Significance:
-
C’ GFP library in SD

below threshold15.13 -
N' NOP1pr-GFP in SD

cytosol94.1042 -
N' TEF2pr-mCherry in SD
cytosol95.0872 -
N' NATIVEpr-GFP in SD
below threshold16.3083 -
N' TEF2pr-VC and Cyto-VN in SD

#N/A0 -
C’ GFP library in SD+DTT

cytosol14.070.92No -
C’ GFP library in SD+H2O2

cytosol14.570.96No -
C’ GFP library in Starvation Media

cytosol14.830.97No -
C’ GFP library on the background of Pup2-DaMP

below threshold -
C’ GFP library on the background of CCT mutant

below threshold15.80971.04397No
